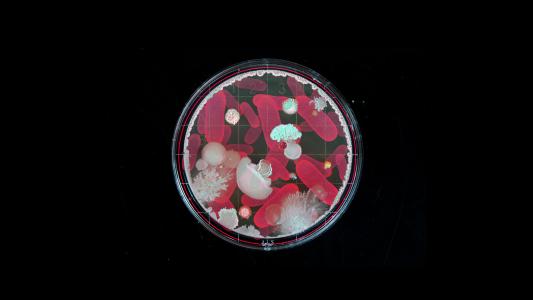

Medicine
“Electronic nose” can detect a cancer precursor on patients’ breath
A new study found that an electronic nose could be an improved screening tool for Barrett’s esophagus, a precursor to esophageal cancer.
How to make 100 million doses of coronavirus vaccine in a year
Creating a new vaccine is slow and expensive. One biotech firm thinks a “plug-and-play” vaccine could change that.
Medical cannabis explained
Medical cannabis is everywhere. We're answering your basic questions and unpacking the promises and pitfalls, based on the latest research.
THC could help women with endometriosis
Hundreds of thousands of women suffer with endometriosis, a disorder that causes painful tissue growth outside of the uterus. Pending clinical trials around THC may finally spell relief.
CRISPR may unlock targeted cannabis therapy
New medicinal cannabis research shows potential for personalized drug therapy, without the side effects.
Scientists are using AI to improve breast cancer screening
Computer scientists at MIT created a new algorithm for breast cancer screening to predict whether a patient will develop the disease in the next 5 years.
Could another measles outbreak open up Pandora’s Box?
The global resurgence of measles has sparked renewed scientific interest in this old foe. If the theory — which is contested — turns out to be true, a measles infection could be less an isolated bout of illness and more a Pandora’s box.
mRNA vaccines could change everything in the fight against disease
Traditional methods of vaccination have come up against difficult challenges. They can also be expensive and time-consuming to produce. New RNA vaccines are faster, cheaper, and safer, and show great potential to meet evolving threats.
Uganda begins massive new Ebola vaccine study
The Ebola outbreak in the Congo is now the second deadliest on record. How can we stop the devastation? A study in Uganda could hold the key for a new vaccine.
Hope grows for patients with spinal cord injuries
Severe spinal cord injuries resulting in total paralysis are usually considered permanent, with no hope of recovery. And yet, in a handful of patients spanning multiple levels of severity, movement is being regained.